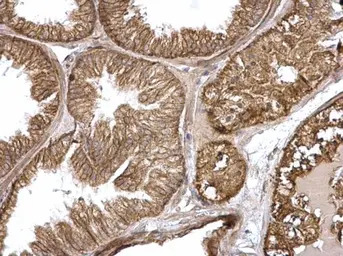
产品细节图片4

相关产品推荐更多 >
万千商家帮你免费找货
0 人在求购买到急需产品
- 详细信息
- 文献和实验
- 技术资料
- 免疫原:
Carrier-protein conjugated synthetic peptide encompassing a sequence within the C-terminus region of human H-Ras. The exact sequence is proprietary.
- 亚型:
IgG
- 形态:
Liquid
- 保存条件:
Store as concentrated solution. Centrifuge briefly prior to opening vial. For short-term storage (1-2 weeks), store at 4ºC. For long-term storage, aliquot and store at -20ºC or below. Avoid multiple freeze-thaw cycles.
- 克隆性:
Polyclonal
- 标记物:
Unconjugated
- 适应物种:
Human, Mouse, Rat
- 保质期:
12 months from the shipping date of the product.
- 抗原来源:
Human
- 目录编号:
GTX116041
- 级别:
Primary Antibodies
- 库存:
Available
- 供应商:
GeneTex
- 宿主:
Rabbit
- 应用范围:
WB, ICC/IF, IHC-P, IP
- 浓度:
1.87 mg/ml (Please refer to the vial label for the specific concentration.)
- 靶点:
This antibody is specific for H-Ras protein, and it does not cross react with human N-Ras or K-Ras protein.
- 抗体英文名:
H-Ras antibody
- 抗体名:
H-Ras 抗体
- 规格:
100 μl/25 μl
| 规格: | 100 μl | 产品价格: | ¥4000.0 |
|---|---|---|---|
| 规格: | 25 μl | 产品价格: | ¥1700.0 |

Various whole cell extracts (30 μg) were separated by 12% SDS-PAGE, and the membrane was blotted with H-Ras antibody (GTX116041) diluted at 1:2000. The HRP-conjugated anti-rabbit IgG antibody (GTX213110-01) was used to detect the primary antibody.

Various tissue extracts (50 μg) were separated by 12% SDS-PAGE, and the membrane was blotted with H-Ras antibody (GTX116041) diluted at 1:2000. The HRP-conjugated anti-rabbit IgG antibody (GTX213110-01) was used to detect the primary antibody.

Whole cell extract (30 μg) was separated by 12% SDS-PAGE, and the membrane was blotted with H-Ras antibody (GTX116041) diluted at 1:1000. The HRP-conjugated anti-rabbit IgG antibody (GTX213110-01) was used to detect the primary antibody.
H-RAS antibody detects H-RAS protein at membrane on mouse intestine by immunohistochemical analysis.
Sample: Paraffin-embedded mouse intestine.
H-RAS antibody (GTX116041) dilution: 1:500.
Antigen Retrieval: Trilogy™ (EDTA based, pH 8.0) buffer, 15min

H-RAS antibody detects H-RAS protein at membrane on mouse intestine by immunohistochemical analysis.
Sample: Paraffin-embedded mouse intestine.
H-RAS antibody (GTX116041) dilution: 1:500.
Antigen Retrieval: Trilogy™ (EDTA based, pH 8.0) buffer, 15min

Various whole cell extracts (30 μg) were separated by 12% SDS-PAGE, and the membranes were blotted with H-RAS antibody (GTX116041) diluted at 1:500 and competitor's antibody (SC-520) diluted at 1:200. The HRP-conjugated anti-rabbit IgG antibody (GTX213110-01) was used to detect the primary antibody.
*The competitor is not affiliated with GeneTex and does not endorse this product.

Non-transfected (–) and transfected (+) 293T whole cell extracts (30 μg) were separated by 12% SDS-PAGE, and the membrane was blotted with H-RAS antibody (GTX116041) diluted at 1:5000. The HRP-conjugated anti-rabbit IgG antibody (GTX213110-01) was used to detect the primary antibody.

Various whole cell extracts (30 μg) were separated by 12% SDS-PAGE, and the membrane was blotted with H-RAS antibody (GTX116041) diluted at 1:1000. The HRP-conjugated anti-rabbit IgG antibody (GTX213110-01) was used to detect the primary antibody.

Immunofluorescence analysis of PFA-fixed HeLa, using H-RAS (GTX116041) antibody at 1:200 dilution.
风险提示:丁香通仅作为第三方平台,为商家信息发布提供平台空间。用户咨询产品时请注意保护个人信息及财产安全,合理判断,谨慎选购商品,商家和用户对交易行为负责。对于医疗器械类产品,请先查证核实企业经营资质和医疗器械产品注册证情况。
 文献和实验
文献和实验Sugita S et al., Int J Oncol 2018 (PMID:29901113)
Sarin N et al., Int J Mol Sci 2018 (PMID:29518977)
Brandt LP et al., PLoS One 2017 (PMID:28982163)
Tsuboi M et al., J Biol Chem 2017 (PMID:28912272)
Antonella Catalano et al., Cancers (Basel) 2021 (PMID:33924486)
Hu W et al., JCI Insight 2021 (PMID:33400686)
Wu HT et al., Am J Chin Med 2020 (PMID:32668964)
Brandt LP et al., Oncotarget 2018 (PMID:29731980)
Gao P et al., Breast Cancer Res 2018 (PMID:30208932)
Adenoviral-Mediated Anti-H-ras Ribozyme for the Treatment of Bladder Cancer
Bladder cancer is the fifth most common malignancy, demonstrated by the approx 52,900 patients that will be diagnosed in the United States in 1996 (1 ). Around 15–20% of these patients will be characterized by muscle invasion or node posmve
Tissue-Specific Delivery of an anti-H-ras Ribozyme Against Malignant Melanoma
Malignant melanoma is an increasingly important clinical problem in the United States, because the incidence of cutaneous malignant melanoma has been increasing significantly in recent years (1 ,2 ) Despite the use of cancer chemotherapy
Ras是大鼠肉瘤(rat sarcoma,Ras)的英文缩写。Ras蛋白是原癌基因 c—ras的表达产物,相对分子质量为21kDa,属单体 GTP结合蛋白,具有弱的 GTP酶活性。Ras蛋白的活性状态对细胞的生长、分化、细胞骨架、蛋白质运输和分泌等都具有影响,其活性则是通过与GTP或GDP的结合进行调节。 Ras的活性受两个蛋白的控制,一个是鸟苷交换因子(guanine nucleotide exchange factor, GEF),它的作用是促使GDP从Ras蛋白
 技术资料
技术资料暂无技术资料 索取技术资料











